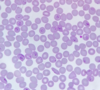
Lyme disease
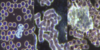
Lyme disease

LYME DISEASE (and FIBROMYALGIA)
In order to offer a professional service to chronic Lyme/fibromyalgia sufferers, half-day and full-day treatments are starting up in October.
Nutritional and functional biology session (1h30) + Russian or American bioresonance treatment (approx. 2h) + heavy metal analysis + dark field/light field/clotted blood/phase contrast microscopy + infrared sauna and a garden facing Lac de Bourget to get in touch with yourself.
Give us a call and tell any chronically ill person about us. There's no need to go abroad and come back as before, but with less strain on your pocket. We can take you seriously at our center!